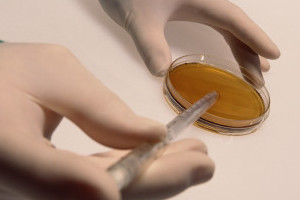
Анализ спермы

Агглютинация в спермограмме может выявиться у любого представителя сильного пола. Патология проявляется разово или постоянно. Опасность такой особенности семенной жидкости заключается в отсутствие беременности в семье. Чтобы выяснить, какие причины мешают зачатию, мужчине и женщине необходимо пройти медицинское обследование. Пациенту необходимо сдать семенную жидкость и кровь из вены. Оба анализа делаются одновременно.
Как возникает патология
Причина проблемы заключается в патологическом составе семенной жидкости. При агглютинации происходит слипание нескольких половых клеток в комок. Это приводит к обездвиживанию сперматозоидов. Они теряют свою способность к оплодотворению.
Если спермограмма показала повышенную агглютинацию, не стоит отчаиваться. Необходимо сдать повторный анализ для подтверждения диагноза.
Нужно учитывать, что данная патология хорошо поддается лечению. Если же причины агглютинации не выясняются, то специалисты проводят дополнительные исследования для положительного зачатия.
Патология подразделяется на две основные формы:
- Истинный тип;
- Ложная патология.
Первая форма характеризуется слипанием половых клеток между собой. При ложной патологии возникает слипание сперматозоида с различными погибшими частицами эпителия, антиспермальными телами или сгустками слизи.
Чтобы выявить, какой тип патологии поразил сперму мужчины, необходимо повторно сдать спермограмму.
Врачи отмечают, что склеивание сперматозоидов, или агглютинация, может быть серьезной проблемой для мужчин, стремящихся к отцовству. Это явление может возникать по различным причинам, включая инфекции, аутоиммунные реакции или нарушения в составе семенной жидкости. Специалисты подчеркивают, что агглютинация может негативно влиять на подвижность сперматозоидов, что, в свою очередь, затрудняет процесс оплодотворения. Важно, чтобы мужчины, столкнувшиеся с этой проблемой, обращались к урологам или андрологам для диагностики и возможного лечения. Современные методы, такие как ИКСИ (интрацитоплазматическая инъекция сперматозоида), могут помочь преодолеть трудности, связанные с агглютинацией, и повысить шансы на успешное зачатие. Врачи рекомендуют регулярные обследования и поддержание здорового образа жизни для снижения риска возникновения подобных нарушений.

Причины, вызывающие склеивание сперматозоидов
Существует огромное количество причин, которые вызывают агглютинацию семенной жидкости. Сперматозоиды могут слипаться под воздействием таких факторов, как:
Травмирование половых органов;
- Гормональные изменения;
- Воспалительные заболевания мочеполовой системы;
- Нарушение работы иммунной системы.
Травмирование половых органов может вызвать смещение или сдавливание органов малого таза. Под влиянием давления, оказываемого смещенным органом, на соседних тканях происходит патологическое изменение. При травмировании нарушается питание тканей, и происходит отмирание их клеток. Процесс сопровождается появлением воспалительного процесса, который и влечет агглютинацию.
Гормональные изменения всегда оказывают вред здоровью половой системы мужчины. Тестостерон отвечает за появление эрекции, выработку сперматозоидов и секрета семенной жидкости. Если уровень тестостерона в крови падает, происходит нарушение сперматогенеза.
Увеличивается риск развития аномальных сперматозоидов, которые не представляют ценности для зачатия. Также нарушается вязкость секрета спермы. Она становится гуще. Спермии плохо передвигаются и прилипают к кусочкам слизи, которые возникают из-за повышения уровня пептидов в сперме.
Различные воспалительные заболевания оказывают патологическое воздействие на состояние здоровья мочеполовой системы. Воспаление половых органов может иметь неясную этиологию или бактериальную. При бактериальной форме патологии возникает инфицирование организма болезнетворными микроорганизмами. Бактерии питаются здоровыми тканями. На участке, заселенном болезнетворными микробами, скапливаются погибшие клетки тканей. Они вызывают воспаление. Воспалительный процесс может протекать как на поверхности органа, так и внутри. Процесс, протекающий в семявыводящих путях, приводит к ложной агглютинации. В данном случае сперматозоиды склеиваются с погибшими тканями.
Частой причиной агглютинации является нарушение работы иммунной системы. Иммунитет человека выполняет функцию щита. Он защищает организм от патогенного воздействия окружающей среды. При прохождении спермы по семявыводящим путям у отдельных пациентов происходит выработка антиспермальных тел. Это связано с ошибочной работой защитной системы. Организм воспринимает половые клетки, как чужеродное тело и начинает на него нападать. При этом происходит выработка тел, которые захватывают спермии и склеивают. У пациента возникает ложная агглютинация.
Как выявить патологию
Многие мужчины начинают задумываться о медицинском обследовании при отсутствии беременности в семье. Для выявления причин бесплодия пациенту рекомендуется сдать спермограмму. Анализ берется при соблюдении ряда правил:
Половой покой;
- Отказ от приема спиртного;
- Отмена сопутствующего лечения.
Половой покой необходимо соблюдать для выявления срока жизнеспособности половой клетки. Средним сроком жизни считается 4–5 дней. На этот период пациент должен отказаться от сексуальных контактов. Если же правило соблюдаться не будет, то анализ считается недействительным. Также половой покой соблюдается для наибольшего скопления сперматозоидов и секрета. Это поможет более точно выяснить причины бесплодия.
Спиртные напитки пагубно влияют на жизнедеятельность половых клеток. Спермии обладают повышенной чувствительностью к алкоголю. При ежедневном употреблении даже небольших доз алкоголя, сперматозоиды погибают. Отказ от алкоголя осуществляется за 3–4 дня до спермограммы.
Многие пациенты находятся на дополнительном лечении от различных хронических заболеваний. Прием некоторых препаратов приводит к аномальному развитию спермиев или их гибели. За одну неделю до спермограммы больному необходимо проконсультироваться со своим лечащим врачом. Он подскажет, можно ли отказаться от сопутствующего лечения на 5–7 дней.
Если анализ был собран правильно, то диагностика будет более точной. При сборе эякулята необходимо учитывать, что сперма меняет свои свойства в течение 20 минут. Сначала сперма имеет жидкую структуру для легкого прохождения по семявыводящим путям. Потом она становится вязкой. Это необходимо для лучшего удержания семенной жидкости во влагалище. Через 20 минут сперма вновь разжижается, чтобы облегчить прохождение сперматозоидов к яйцеклетке. Поэтому специалисты требуют, чтобы эякулят был собран не позднее чем за три часа до исследования. Также нужно учитывать погодные условия. Семенная жидкость не должна повергаться перегреву или переохлаждению. Перепады температур могут привести к полной гибели половых клеток.
После изучения спермограммы специалисты назначают бактериальный посев мазка. Данный анализ поможет выявить этиологию заболевания. При бактериальном посеве можно обнаружить взрослые особи болезнетворных микроорганизмов или продукты их жизнедеятельности. Если в мазке мужчины бактерии не обнаруживаются, то лечение заключается в подборе методов оплодотворения яйцеклетки.
Склеивание сперматозоидов, или агглютинация, вызывает множество обсуждений в медицинских и научных кругах. Многие мужчины, столкнувшиеся с этой проблемой, выражают беспокойство о своем репродуктивном здоровье. Врачи объясняют, что агглютинация может быть связана с инфекциями, аутоиммунными реакциями или даже с неправильной подготовкой к анализам. Некоторые пациенты отмечают, что после лечения и изменения образа жизни, например, отказа от вредных привычек, ситуация улучшилась. Однако важно помнить, что каждый случай индивидуален, и необходима консультация специалиста. Обсуждения на форумах показывают, что многие ищут поддержку и информацию, чтобы лучше понять свое состояние и возможные пути решения проблемы.

Методы устранения проблемы

- Медикаментозное воздействие;
- Хирургическое влияние.
Медикаментозная терапия назначается при выявлении воспалительного процесса. Для устранения бактерии, вызвавшей склеивание спермиев и гибель тканей, необходимо пить антибиотики. Часто специалисты используют антибиотические препараты широкого спектра действия. Они способны одновременно уничтожить различные группы микробов. После антибиотиков пациенту назначаются нестероидные противовоспалительные лекарственные средства. Они убирают воспаление, и снижают тонус тканей. Это помогает организму быстрее очиститься от погибших тканей и восстановиться сперме.
Хирургическое воздействие назначается при поражении семявыводящих путей сосудистыми патологиями. Варикоцеле третьей и второй степени приводит к изменению структуры и состава спермы. Устранить патологию можно только хирургическим методом. Также операцию назначают при перекруте яичка или аденоме предстательной железы в последней стадии.
Агглютинация может и не поддаваться лечению. В этом случае специалисты подбирают методы оплодотворения для пары.
Для первого оплодотворения специалисты проводят промывку эякулята. Здоровые подвижные клетки отделяются о мертвых и склеенных и сохраняются в секрете. Погибшие клетки вымываются. Очищенная жидкость вводится в тело матки при помощи специального шприца. Если оплодотворение не наступает, то пара направляется на экстракорпоральное оплодотворение. В этом случае сперматозоид вводится в яйцеклетку микроиглой.

Если в семье длительное время не происходит зачатие, то необходима помощь врачей. Агглютинация в спермограмме может стать одной из патологических причин, препятствующих оплодотворению.
Вопрос-ответ
Можно ли забеременеть, если у мужчины агглютинация?
Агглютинация ограничит движения сперматозоидов, а значит, вероятность попадания их в маточные трубы и яйцеклетку. Т. е. снизит вероятность зачатия ребенка. Выраженность агглютинации есть разная — отражается в спермограммах в виде «+» от 1 до 4. Чем выше количество «плюсов», тем хуже результат.
От чего возникает агглютинация?
Причины появления агглютинации: инфекционные заболевания (сифилис, гонорея, хламидиоз, ВИЧ-инфекция), дефицит витамина С, высокая концентрация сперматозоидов в эякуляте, изменение реакции среды при воспалительных и инфекционных процессах.
Означает ли наличие комковатой спермы бесплодие?
Коагуляция спермы, не влияя на общее состояние здоровья или сексуальную функцию, может привести к бесплодию у мужчин. Поэтому, если вы заметили какие-либо необычные симптомы, важно незамедлительно обратиться к врачу, чтобы определить причину и получить соответствующее лечение.
Советы
СОВЕТ №1
Изучите основы репродуктивной биологии. Понимание процесса оплодотворения и роли сперматозоидов поможет вам лучше осознать, как и почему происходит склеивание. Это знание может быть полезным для дальнейшего изучения тем, связанных с фертильностью и репродуктивным здоровьем.
СОВЕТ №2
Обратите внимание на факторы, влияющие на качество спермы. Здоровый образ жизни, включая сбалансированное питание, регулярные физические нагрузки и отказ от вредных привычек, может значительно улучшить качество сперматозоидов и снизить риск их склеивания.
СОВЕТ №3
Консультируйтесь с врачом при возникновении проблем с фертильностью. Если вы замечаете трудности с зачатием, важно обратиться к специалисту, который сможет провести необходимые анализы и предложить эффективные методы лечения, включая возможные способы борьбы со склеиванием сперматозоидов.

 Травмирование половых органов;
Травмирование половых органов;
Половой покой;
Половой покой;






